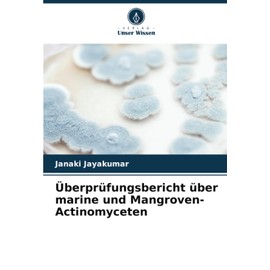
Überprüfungsbericht über marine und Mangroven-Actinomyceten

Frontpage of vendor Cbizocta2


An Universal Dictionary of the Marine
$137.71
$139.04


Palmolive Lemon Lime Dishwashing Liquid 500 ml
$39.13
$39.21